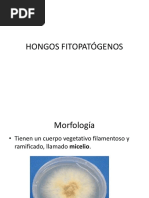

0% encontró este documento útil (0 votos)
67 vistas2 páginasTaxonomía de Los Hongos
Este documento clasifica los hongos en 4 clases principales basadas en sus características reproductivas: Ficomicetes producen esporas asexuales contenidas en esporangios; Ascomicetes producen conidias asexualmente e ascosporas sexualmente en ascocarpos; Basidiomicetes producen basidiosporas sexuales en basidios; y Hongos Imperfectos se clasifican por sus conidias y esporangios asexuales. Cada clase incluye ejemplos de géneros de hongos y el tipo de esporas que
Cargado por
Belen ReyesDerechos de autor
© © All Rights Reserved
Nos tomamos en serio los derechos de los contenidos. Si sospechas que se trata de tu contenido, reclámalo aquí.
Formatos disponibles
Descarga como DOCX, PDF, TXT o lee en línea desde Scribd
0% encontró este documento útil (0 votos)
67 vistas2 páginasTaxonomía de Los Hongos
Este documento clasifica los hongos en 4 clases principales basadas en sus características reproductivas: Ficomicetes producen esporas asexuales contenidas en esporangios; Ascomicetes producen conidias asexualmente e ascosporas sexualmente en ascocarpos; Basidiomicetes producen basidiosporas sexuales en basidios; y Hongos Imperfectos se clasifican por sus conidias y esporangios asexuales. Cada clase incluye ejemplos de géneros de hongos y el tipo de esporas que
Cargado por
Belen ReyesDerechos de autor
© © All Rights Reserved
Nos tomamos en serio los derechos de los contenidos. Si sospechas que se trata de tu contenido, reclámalo aquí.
Formatos disponibles
Descarga como DOCX, PDF, TXT o lee en línea desde Scribd